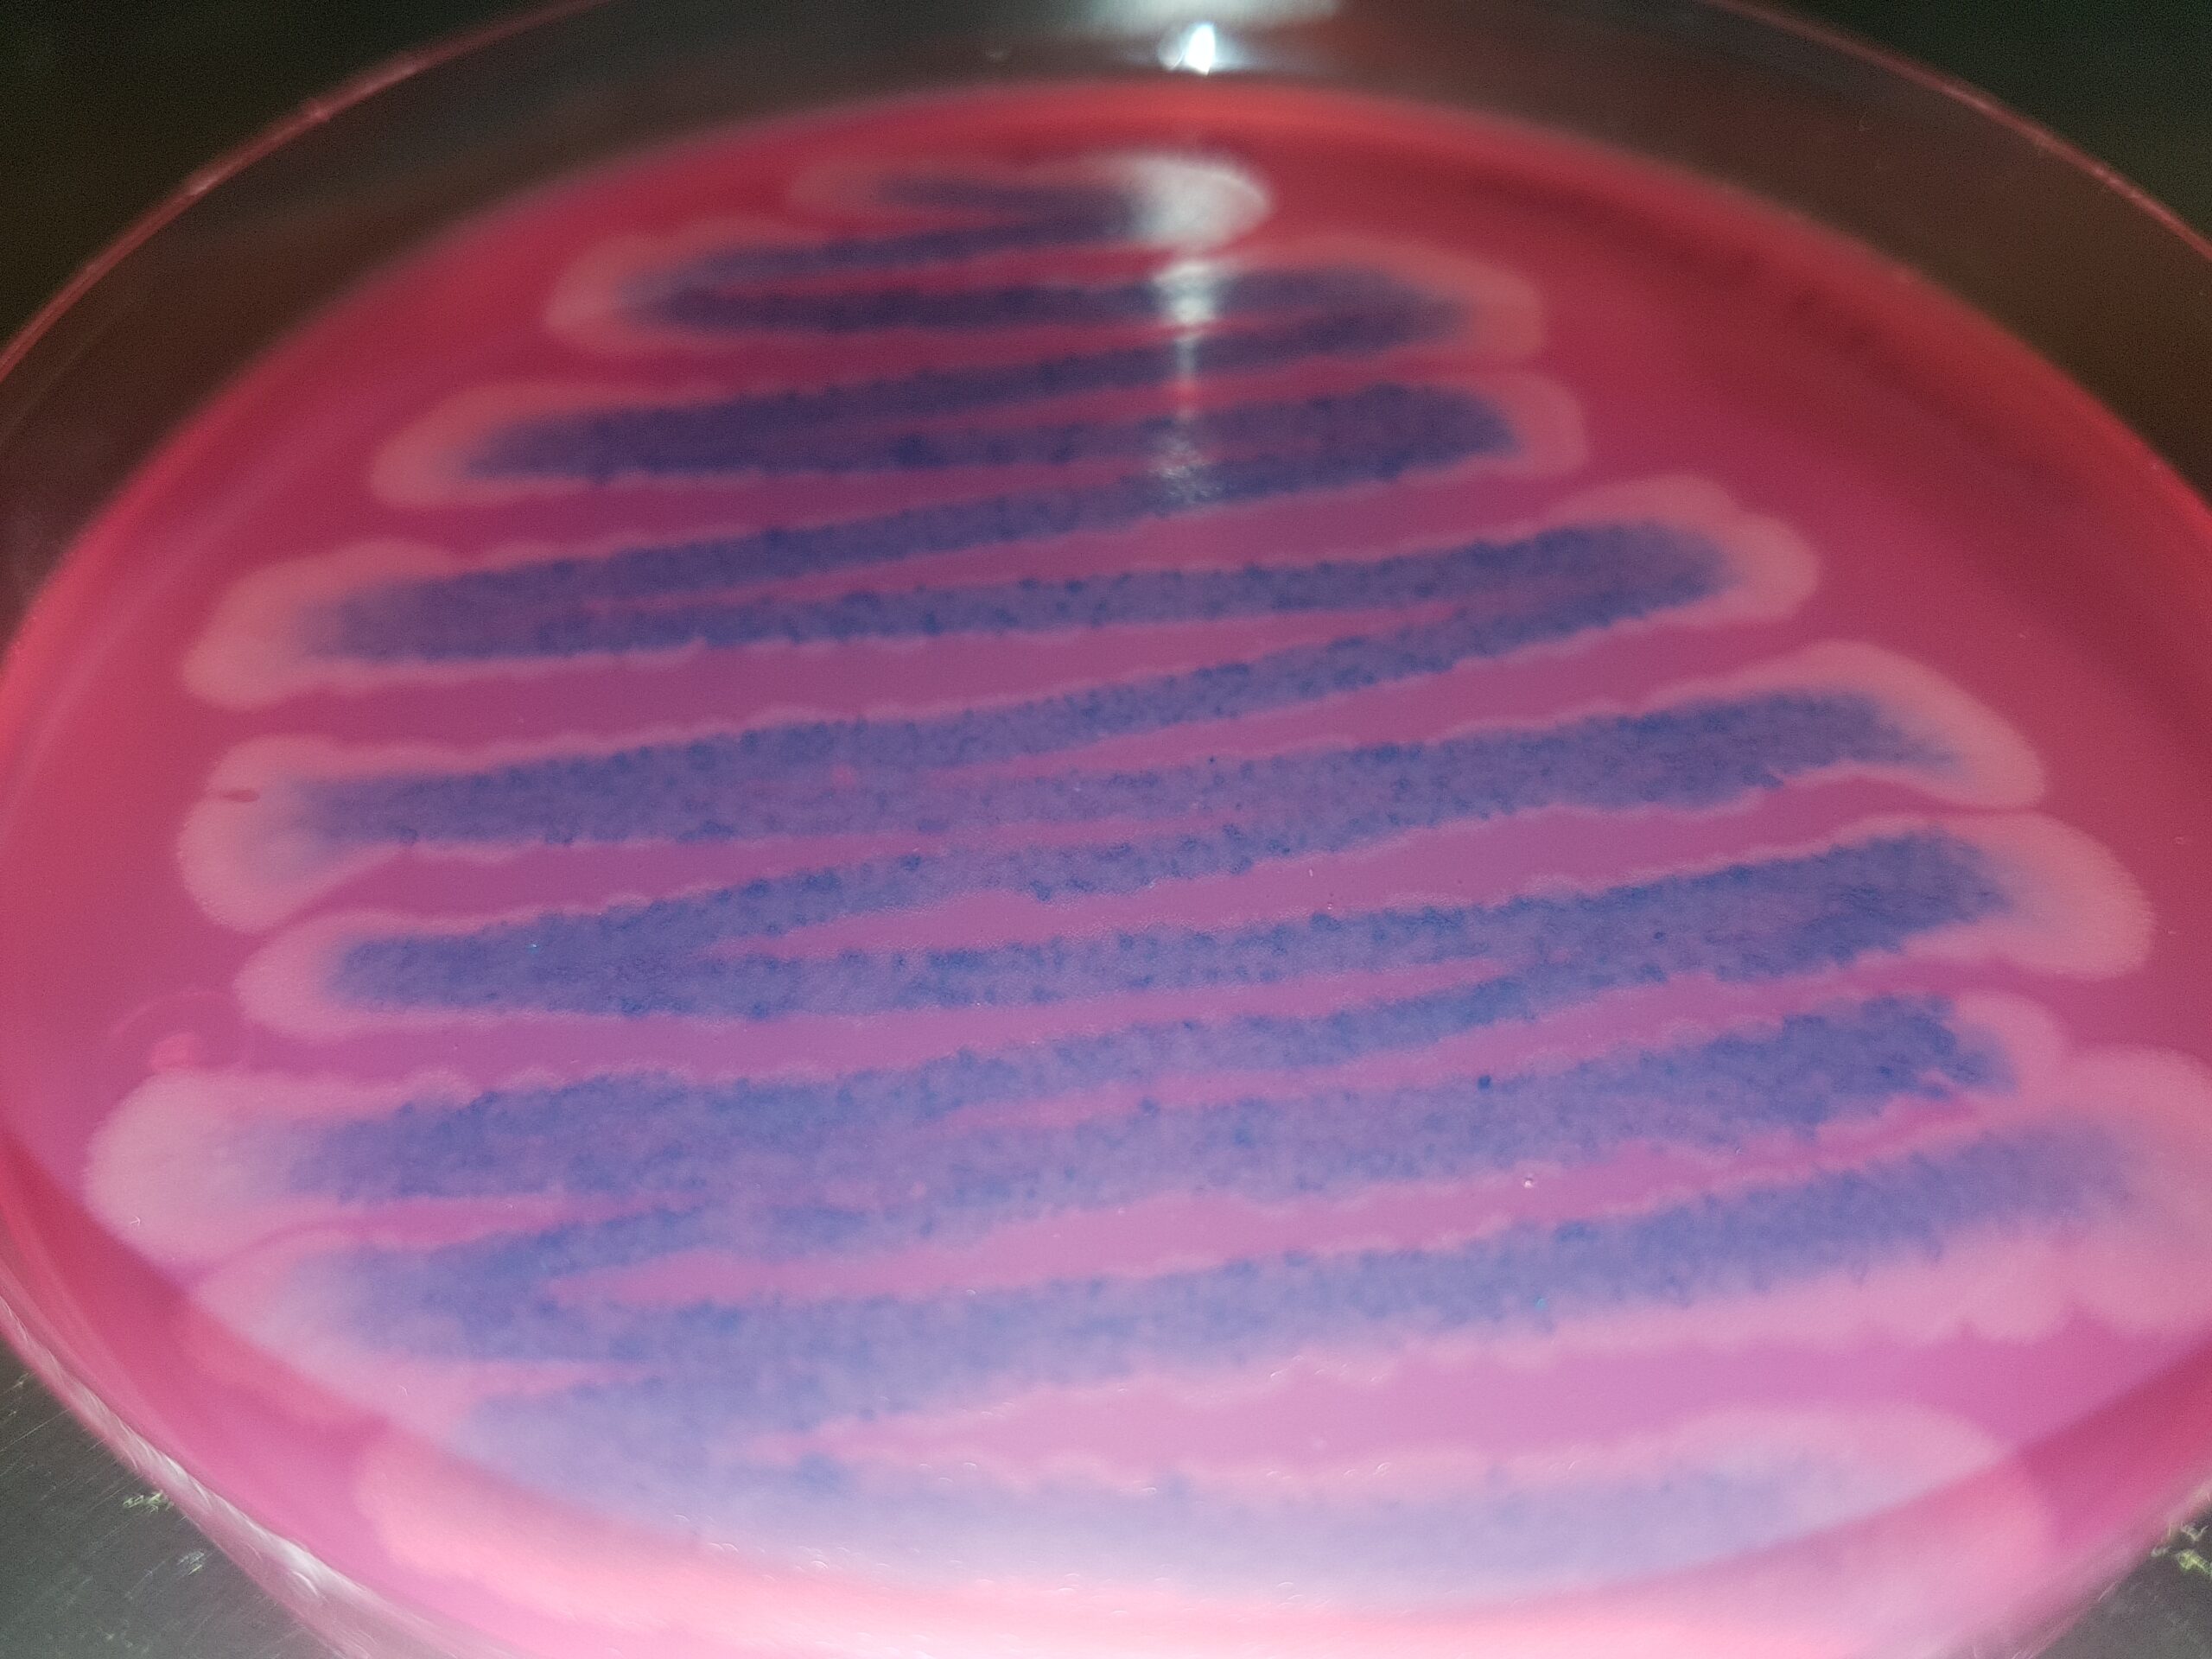

Cepa de Bacillus cereus, cuantitativa, para control de calidad de medios y kits, para detectar adecuadamente este ubicuo patógeno
Cepa de Bacillus cereus
Bacillus cereus es una bacteria Gram positiva, esporulada, patógena y ubicua.
Para conocer más de esta cepa recomendamos ver nuestro monográfico inmediatamente después de ver el presente:
https://www.medioscultivo.com/bacillus/
Si su laboratorio es de los que buscan este patógeno, necesitará comprobar que los medios que emplea son capaces de detectarlo adecuadamente. Por eso la cepa de Bacillus cereus se considera material de referencia, porque gracias a ella podrá conocer si la calidad de los medios y kits que utiliza es correcta.
Cepas disponibles en stock para entrega inmediata
MICROKIT pone a su disposición la cepa cuantitativa de Bacillus cereus en formato lentícula estabilizada, con el doble de vida útil que la mayoría de cepas cuantitativas (en nuestro caso, 2 años de caducidad desde fabricación):
WDCM 00001
Normalmente disponemos de ella a una concentración cercana a 10E4 ufc/lentícula que, al disolverse en un tubo de 10 mL de Ringer marino o solución salina, proporcionará un inóculo de 10E3/mL o de 10E2/0,1 mL
Con excelente capacidad de conservación, dado que las fabricamos con un sistema que no las maltrata, como lo hace la liofilización, sino que las mima.
Tambien disponible, entre otras muchas, la cepa de otro Bacillus:
Bacillus subtilis subsp. spizizenii WDCM 00003, que Farmacopea menciona con el número de la colección USA 6633
Medios de cultivo para detectar Bacillus cereus
El medio más usado para su aislamiento en placa, por su mención en la Norma ISO 7932 y demás bibliografía, es el Agar Mossel (tambien conocido como MYP y PREP (Polimixina, Rojo Fenol, Yema y Manitol Agar):
https://www.microkit.es/fichas/BACILLUS-CEREUS-MOSSEL-AGAR.pdf
En la foto se observa su aspecto típico en este medio: colonias con aspecto de gota de vela, que viran el medio de su original color salmón al rosa fucsia
En el siglo de los medios cromogénicos, no podía faltar el Cromokit-BC Agar, con base Mossel y un cromógeno que vira el centro de las colonias de B.cereus a azul; el medio como buen Mossel, vira de salmón a fucsia:
https://www.microkit.es/fichas/CROMOKIT-B-CEREUS-AGAR.pdf
También se emplea este medio en el kit de detección de Bacillus cereus en las superficies de las fábricas de alimentos:
https://www.microkit.es/fichas/B-CEREUS-XSWABBS-UE-2-2019.pdf
Confirmación de colonias sospechosas
La galerías de identificación que existen para el género Bacillus están muy obsoletas e incompletas. Por ello es mejor emplear directamente un kit que diga si se trata o no de B.cereus, como nuestro M-Ident B.cereus:
https://www.microkit.es/fichas/BACILLUS-CEREUS-M-IDENT-KIT-ISO-7932-UE-2-2019-ALIMENTOS.pdf
Contacto
Todas estos medios y kits mencionados, así como la cepa (y otras muchas), los tenemos en nuestras instalaciones en stock para entrega inmediata. Solicite la lista actualizada de stock de cepas cuantitativas para consultar las concentraciones y caducidades, antes de realizar sus pedidos, en microkit@microkit.es.
Consulte el folleto:
https://www.microkit.es/pdf/CEPAS-CUANTITATIVAS-2022.pdf
y el video:
Haga sus pedidos de cepas en: pedidos@microkit.es
Cepas cuantitativas de MICROKIT, la únicas lentículas cuantitativas fabricadas en España, desde hace más de 15 años, bajo Norma ISO 9001 y siguiendo las directrices sobre la competencia de los fabricantes de material de referencia (ISO 17034).